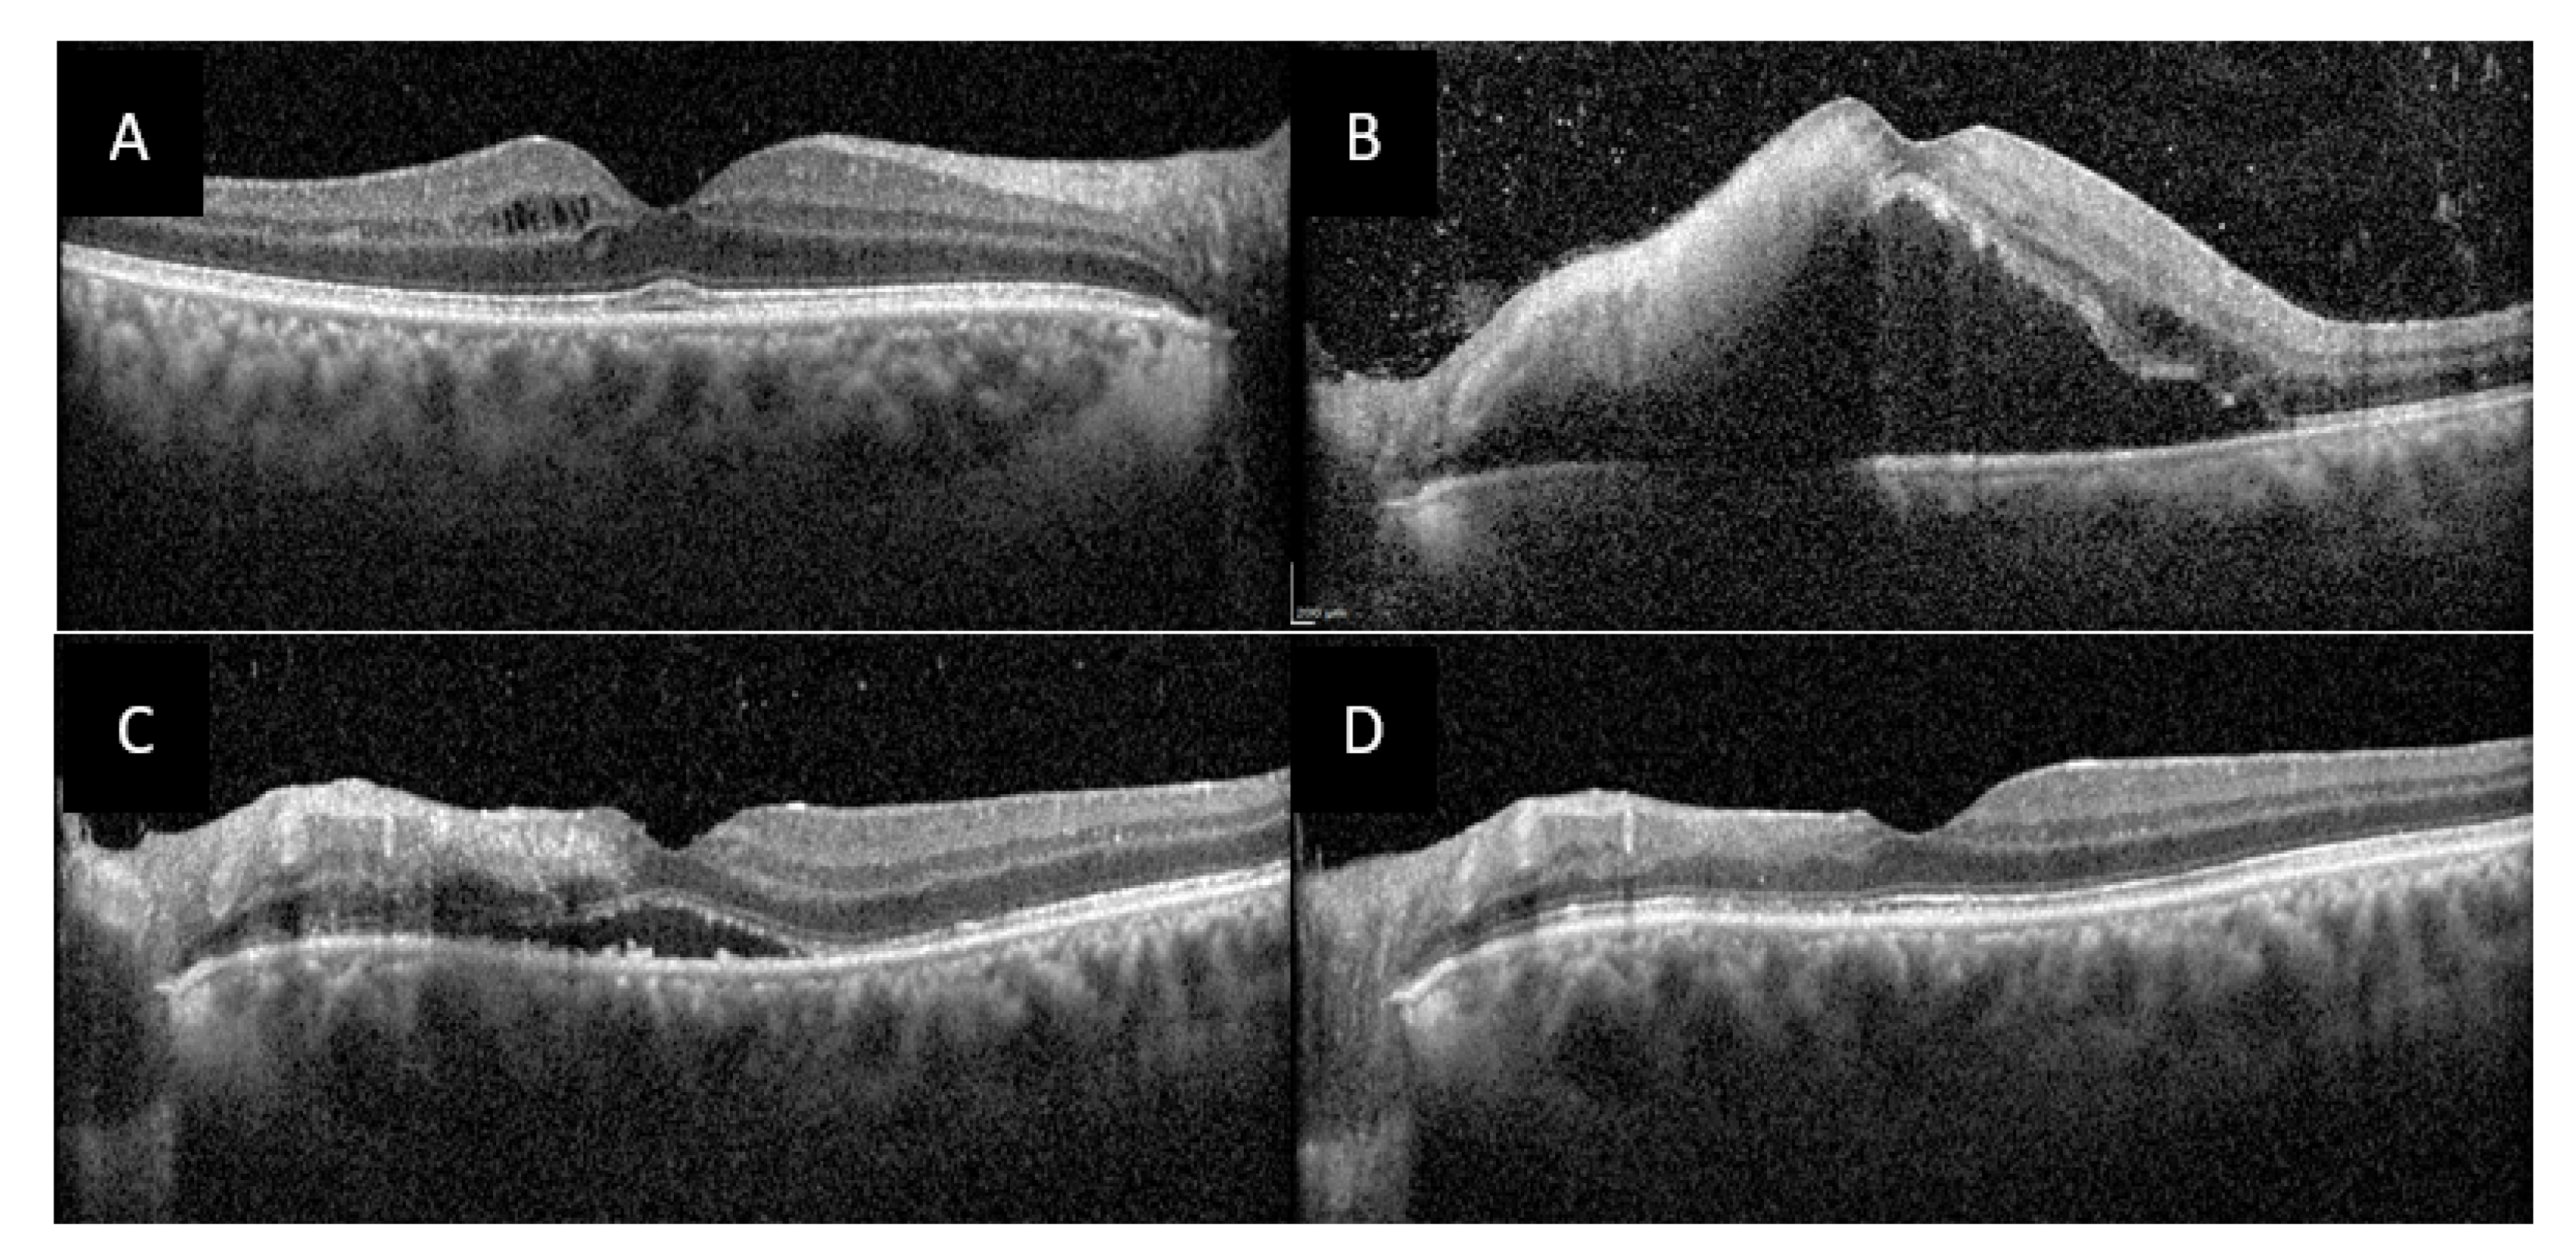

Uveitis as an Open Window to Systemic Inflammatory Diseases
Abstract
1. Introduction
| Etiology | Specific Causes |
|---|---|
| Infectious diseases | Bacterial: syphilis, tuberculosis, Lyme disease, cat-scratch disease, rickettsiosis, leptospirosis, brucellosis, Whipple’s disease [30], chlamydiosis, tularemia, post-streptococcal [31] Parasitic: toxoplasmosis, toxocariasis, onchocerciasis, cysticercosisViral: herpes simplex viruses 1 and 2, CMV, HTLV-1, Dengue virus, Ebola virus, Zika virus, West-Nile virus, Rift valley fever virus, chikungunya virus, coronaviruses [32] Fungal: candidiasis, histoplasmosis, aspergillosis, cryptococcosis |
| Inflammatory diseases | HLA-B27-associated uveitis/spondyloarthritis Chronic inflammatory bowel diseases Sarcoidosis Behçet’s disease Vogt–Koyanagi–Harada disease Multiple sclerosis and anti-myelin oligodentrocyte glycoprotein (anti-MOG)-associated disease [33] Juvenile idiopathic arthritis Tubulointerstitial nephritis and uveitis (TINU syndrome) Celiac disease [34] Systemic lupus erythematosus, systemic vasculitides (Kawasaki disease, polyarteritis nodosa, granulomatosis with polyangiitis, giant cell arteritis) Monogenic autoinflammatory diseases: Blau syndrome, cryopyrine-associated periodic syndromes, A20 haploinsufficiency [35] Common variable immunodeficiency [36] IgG4-related disease [37] Kikuchi–Fujimoto disease [38] Sweet’s syndrome [39] Autoimmune lymphoproliferative syndrome [40] |
| Pseudo-uveitis | Trauma, intraocular foreign body Cancer (oculocerebral lymphoma, melanoma, retinoblastoma, leukemia, metastasis) |
| Ophthalmologic entities | Birdshot chorioretinopathy Multifocal choroiditis Pars planitis Fuchs heterochromic cyclitis Phacoantigenic uveitis Posner–Schlossman syndrome Other white dot syndromes (placoid epitheliopathy, serpiginoid choroiditis) Sympathetic ophthalmia |
| Drug-induced uveitis | Rifabutin Biphosphonates Anti-tumor necrosis factor-α IFN-α or -β BCG therapy Cancer immunotherapy: BRAF and MEK inhibitors, CTLA4 and PD-1/PD-L1 checkpoint inhibitors [41] Vaccines [42] |
| Biomarker | Test Performance/Usefulness | Limitations/Comments | References | ||
|---|---|---|---|---|---|
| Lymphopenia (lymphocyte count <1000/mm3) * | Se/Sp | PPV/NPV | YI/AUC | Poor Youden’s index. Test performances based on lymphocyte count cutoff. Better performance coupled with serum ACE. | [43] |
| 0.15/0.97 | 0.48/0.85 | 0.12/0.71 | |||
| Increased sensitivity (0.19), specificity (0.99) and NPV (0.90) when associated with elevated ACE. Increased sensitivity (0.75) but lower specificity (0.77) with 1470/mm3 cutoff. Easily accessible, simple, and non-invasive. | |||||
| Elevated ACE * (>52–61 UI/l) | Se/Sp | PPV/NPV | YI/AUC | Optimal cutoff varying from 52 UI/l to 61 UI/l. Uninterpretable if patient uses ACE inhibitors. | [43,44] |
| 0.45–0.78/0.9 | 0.44/0.89–0.97 | 0.35–0.68 | |||
| Highly specific and high NPV in patients referred for uveitis with no known cause. Increased sensitivity/specificity coupled with lymphopenia. | |||||
| sIL-2R (threshold according to manufacturer) | Se/Sp | PPV/NPV | YI | Not used widely enough (not validated in revised IWOS criteria). No validated threshold. | [45] |
| 0.98/0.94 | 0.77/0.99 | 0.92 | |||
| Very sensitive, high NPV, good YI. sIL2R levels replaced negative tuberculin skin test in Japanese diagnostic criteria for sarcoidosis. | |||||
| Lysozyme * | Sensibility: 0.60–78; sensitivity: 76–95. In systemic sarcoidosis, lysozyme levels are positively correlated with sIL-2R levels and ACE levels. | High lysozyme levels can be found in infectious uveitis (tuberculosis, syphilis). | [46,47] | ||
| Chitotriosidase activity | No data in sarcoidosis uveitis. In patients with systemic sarcoidosis, 48.8 nmol/h/mL cutoff is associated with 0.89 sensitivity and 0.93 specificity. | High chitotriosidase activity reported in other pulmonary diseases (COPD, asbestosis). Not easily available. | [48] | ||
2. Experimental Section
2.1. Methods
2.2. Spondyloarthritis
2.2.1. Case Report
2.2.2. Ophthalmic Features and Diagnosis
2.2.3. Treatment
2.3. Behçet’s Disease
2.3.1. Case Report
2.3.2. Ophthalmic Features and Diagnosis
2.3.3. Treatment
2.4. Sarcoidosis
2.4.1. Case Report
2.4.2. Ophthalmic Features and Diagnosis
2.4.3. Treatment
3. Discussion
Author Contributions
Funding
Institutional Review Board Statement
Informed Consent Statement
Data Availability Statement
Acknowledgments
Conflicts of Interest
References
- Prete, M.; Dammacco, R.; Fatone, M.C.; Racanelli, V. Autoimmune uveitis: Clinical, pathogenetic, and therapeutic features. Clin. Exp. Med. 2015, 16, 125–136. [Google Scholar] [CrossRef] [PubMed]
- Gritz, D.C. Incidence and prevalence of uveitis in Northern California The Northern California Epidemiology of Uveitis Study. Ophthalmology 2004, 111, 491–500. [Google Scholar] [CrossRef] [PubMed]
- Rim, T.H.; Kim, S.S.; Ham, D.-I.; Yu, S.-Y.; Chung, E.J.; Lee, S.C. Incidence and prevalence of uveitis in South Korea: A nationwide cohort study. Br. J. Ophthalmol. 2017, 102, 79–83. [Google Scholar] [CrossRef] [PubMed]
- Thorne, J.E.; Suhler, E.; Skup, M.; Tari, S.; Macaulay, D.; Chao, J.; Ganguli, A. Prevalence of Noninfectious Uveitis in the United States. JAMA Ophthalmol. 2016, 134, 1237–1245. [Google Scholar] [CrossRef]
- Dick, A.D.; Rosenbaum, J.T.; Al-Dhibi, H.A.; Belfort, R.; Brézin, A.P.; Chee, S.-P.; Davis, J.L.; Ramanan, A.V.; Sonoda, K.-H.; Carreño, E.; et al. Guidance on Noncorticosteroid Systemic Immunomodulatory Therapy in Noninfectious Uveitis. Ophthalmology 2018, 125, 757–773. [Google Scholar] [CrossRef]
- Pirani, V.; Pelliccioni, P.; De Turris, S.; Rosati, A.; Franceschi, A.; Cesari, C.; Nicolai, M.; Mariotti, C.; Turris, D. The Eye as a Window to Systemic Infectious Diseases: Old Enemies, New Imaging. J. Clin. Med. 2019, 8, 1392. [Google Scholar] [CrossRef]
- Kitamei, H.; Kitaichi, N.; Namba, K.; Kotake, S.; Goda, C.; Kitamura, M.; Miyazaki, A.; Ohno, S. Clinical features of intraocular inflammation in Hokkaido, Japan. Acta Ophthalmol. 2009, 87, 424–428. [Google Scholar] [CrossRef]
- Yang, P.; Zhong, Z.; Du, L.; Li, F.; Chen, Z.; Zhu, Y.; Zhang, W.; Huang, F.; Ye, X.; Su, G.; et al. Prevalence and clinical features of systemic diseases in Chinese patients with uveitis. Br. J. Ophthalmol. 2021, 105, 75–82. [Google Scholar] [CrossRef]
- Yalçındağ, F.N.; Özdal, P.C.; Özyazgan, Y.; Batıoğlu, F.; Tugal-Tutkun, I. on behalf of the BUST Study Group Demographic and Clinical Characteristics of Uveitis in Turkey: The First National Registry Report. Ocul. Immunol. Inflamm. 2018, 26, 17–26. [Google Scholar] [CrossRef]
- Zagora, S.L.; Symes, R.; Yeung, A.; Yates, W.B.; Wakefield, D.; McCluskey, P. Etiology and Clinical Features of Ocular Inflammatory Diseases in a Tertiary Referral Centre in Sydney, Australia. Ocul. Immunol. Inflamm. 2016, 25, 1–8. [Google Scholar] [CrossRef]
- Khairallah, M.; Ben Yahia, S.; Ladjimi, A.; Messaoud, R.; Zaouali, S.; Attia, S.; Jenzeri, S.; Jelliti, B. Pattern of uveitis in a referral centre in Tunisia, North Africa. Eye 2006, 21, 33–39. [Google Scholar] [CrossRef]
- Sukavatcharin, S.; Kijdaoroong, O.; Lekhanont, K.; Vallipakorn, S.A.-O. Pattern of Uveitis in a Tertiary Ophthalmology Center in Thailand. Ocul. Immunol. Inflamm. 2017, 25, S94–S99. [Google Scholar] [CrossRef] [PubMed]
- Biswas, J.; Sitaula, R.K.; Multani, P. Changing uveitis patterns in South India—Comparison between two decades. Indian J. Ophthalmol. 2018, 66, 524–527. [Google Scholar] [CrossRef] [PubMed]
- De-La-Torre, A.; López-Castillo, C.A.; Rueda, J.C.; Mantilla, R.D.; Gómez-Marín, J.E.; Anaya, J.-M. Clinical patterns of uveitis in two ophthalmology centres in Bogota, Colombia. Clin. Exp. Ophthalmol. 2009, 37, 458–466. [Google Scholar] [CrossRef] [PubMed]
- Chen, E.J.; Bin Ismail, M.A.; Mi, H.; Ho, S.L.; Lim, W.K.; Teoh, S.C.; Agrawal, R. Ocular Autoimmune Systemic Inflammatory Infectious Study (OASIS)—Report 1: Epidemiology and Classification. Ocul. Immunol. Inflamm. 2016, 26, 732–746. [Google Scholar] [CrossRef]
- Abad, S.; Seve, P.; Dhote, R.; Brézin, A.-P. Uvéites et médecine interne: Stratégies diagnostique et thérapeutique. Rev. Médecine Interne 2009, 30, 492–500. [Google Scholar] [CrossRef]
- Keino, H.; Nakashima, C.; Watanabe, T.; Taki, W.; Hayakawa, R.; Sugitani, A.; Okada, A.A. Frequency and clinical features of intraocular inflammation in Tokyo. Clin. Exp. Ophthalmol. 2009, 37, 595–601. [Google Scholar] [CrossRef] [PubMed]
- Bertrand, P.-J.; Jamilloux, Y.; Ecochard, R.; Richard-Colmant, G.; Gerfaud-Valentin, M.; Guillaud, M.; Denis, P.; Kodjikian, L.; Sève, P. Uveitis: Autoimmunity… and beyond. Autoimmun. Rev. 2019, 18, 102351. [Google Scholar] [CrossRef] [PubMed]
- Cunningham, E.T.; Tallstedt, L. Epidemiology of uveitis in a region of southern Sweden. Acta Ophthalmol. 2020, 98, 32–35. [Google Scholar] [CrossRef]
- Rothova, A.; Hajjaj, A.; De Hoog, J.; Thiadens, A.A.; Dalm, V.A. Uveitis causes according to immune status of patients. Acta Ophthalmol. 2019, 97, 53–59. [Google Scholar] [CrossRef] [PubMed]
- Luca, C.; Aldigeri, R.; Sylvia, M.; Valentina, M.; Fabiana, V.; Marco, C.; Annamaria, S.; Savoldi, L.; Alessandro, D.F.; Lucia, B.; et al. Changes in patterns of uveitis at a tertiary referral center in Northern Italy: Analysis of 990 consecutive cases. Int. Ophthalmol. 2017, 38, 133–142. [Google Scholar] [CrossRef] [PubMed]
- Bodaghi, B.; Cassoux, N.; Wechsler, B.; Hannouche, D.; Fardeau, C.; Papo, T.; Huong, D.L.T.; Piette, J.-C.; LeHoang, P. Chronic Severe Uveitis. Medicine 2001, 80, 263–270. [Google Scholar] [CrossRef] [PubMed]
- Llorenç, V.; Mesquida, M.; De La Maza, M.S.; Keller, J.; Molins, B.; Espinosa, G.; Hernández, M.V.; Gonzalez-Martin, J.; Adán, A. Epidemiology of uveitis in a Western urban multiethnic population. The challenge of globalization. Acta Ophthalmol. 2015, 93, 561–567. [Google Scholar] [CrossRef] [PubMed]
- Jakob, E.; Reuland, M.S.; Mackensen, F.; Harsch, N.; Fleckenstein, M.; Lorenz, H.; Max, R.; Becker, M.D. Uveitis Subtypes in a German Interdisciplinary Uveitis Center—Analysis of 1916 Patients. J. Rheumatol. 2009, 36, 127–136. [Google Scholar] [CrossRef] [PubMed]
- Jones, N.P. The Manchester Uveitis Clinic: The First 3000 Patients—Epidemiology and Casemix. Ocul. Immunol. Inflamm. 2013, 23, 118–126. [Google Scholar] [CrossRef]
- Oruc, S.; Kaplan, A.D.; Galen, M.; Kaplan, H.J. Uveitis referral pattern in a Midwest University Eye Center. Ocul. Immunol. Inflamm. 2003, 11, 287–298. [Google Scholar] [CrossRef]
- Bajwa, A.; Osmanzada, D.; Osmanzada, S.; Khan, I.; Patrie, J.; Wenjun, X.; Reddy, A.K.; Xin, W. Epidemiology of uveitis in the mid-Atlantic United States. Clin. Ophthalmol. 2015, 9, 889–901. [Google Scholar] [CrossRef]
- Barisani-Asenbauer, T.; Maca, S.M.; Mejdoubi, L.; Emminger, W.; Machold, K.P.; Auer, H. Uveitis- a rare disease often associated with systemic diseases and infections—A systematic review of 2619 patients. Orphanet J. Rare Dis. 2012, 7, 57. [Google Scholar] [CrossRef]
- De Parisot, A.; Kodjikian, L.; Errera, M.-H.; Sedira, N.; Héron, E.; Pérard, L.; Cornut, P.-L.; Schneider, C.; Rivière, S.; Ollé, P.; et al. Randomized Controlled Trial Evaluating a Standardized Strategy for Uveitis Etiologic Diagnosis (ULISSE). Am. J. Ophthalmol. 2017, 178, 176–185. [Google Scholar] [CrossRef]
- Testi, I.; Tognon, M.S.; Gupta, V. Ocular Whipple Disease: Report of Three Cases. Ocul. Immunol. Inflamm. 2019, 27, 1117–1120. [Google Scholar] [CrossRef]
- Curragh, D.S.; McAvoy, C.E.; Rooney, M.; McLoone, E. Post-streptococcal uveitis syndrome in a Caucasian population: A case series. Eye 2019, 33, 380–384. [Google Scholar] [CrossRef] [PubMed]
- Bettach, E.; Zadok, D.; Weill, Y.; Brosh, K.; Hanhart, J. Bilateral anterior uveitis as a part of a multisystem inflammatory syndrome secondary to COVID-19 infection. J. Med. Virol. 2021, 93, 139–140. [Google Scholar] [CrossRef] [PubMed]
- Spadaro, M.; Gerdes, L.A.; Krumbholz, M.; Ertl-Wagner, B.; Thaler, F.S.; Schuh, E.; Metz, I.; Blaschek, A.; Dick, A.; Brück, W.; et al. Autoantibodies to MOG in a distinct subgroup of adult multiple sclerosis. Neurol. Neuroimmunol. Neuroinflammation 2016, 3, e257. [Google Scholar] [CrossRef] [PubMed]
- Fousekis, F.S.; Katsanos, A.; Katsanos, K.H.; Christodoulou, D. Ocular manifestations in celiac disease: An overview. Int. Ophthalmol. 2020, 40, 1049–1054. [Google Scholar] [CrossRef] [PubMed]
- Bascherini, V.; Granato, C.; Lopalco, G.; Emmi, G.; Vannozzi, L.; Bacherini, D.; Franceschini, R.; Iannone, F.; Salerni, A.; Molinaro, F.; et al. The protean ocular involvement in monogenic autoinflammatory diseases: State of the art. Clin. Rheumatol. 2015, 34, 1171–1180. [Google Scholar] [CrossRef]
- Pasquet, F.; Kodjikian, L.; Mura, F.; Riviere, S.; Harroche, J.; Blanc, A.-P.; Chaix, F.; Oksenhendler, E.; Seve, P. For the DEF-I study group Uveitis and Common Variable Immunodeficiency: Data from the DEF-I Study And Literature Review. Ocul. Immunol. Inflamm. 2012, 20, 163–170. [Google Scholar] [CrossRef]
- Derzko-Dzulynsky, L. IgG4-related disease in the eye and ocular adnexa. Curr. Opin. Ophthalmol. 2017, 28, 617–622. [Google Scholar] [CrossRef]
- Gómez-Mariscal, M.; Oleñik, A.; Arriba-Palomero, P.; García-Cosio, M.; Muñoz-Negrete, F.J. Recurrent Bilateral Anterior Uveitis with Kikuchi–Fujimoto Disease. Ocul. Immunol. Inflamm. 2016, 25, 1–4. [Google Scholar] [CrossRef]
- Kato, K.; Namiki, T.; Tokoro, S.; Miura, K.; Yokozeki, H. Histiocytoid Sweet syndrome with ophthalmologic involvements: A novel association with uveitis. J. Dermatol. 2017, 44, 216–217. [Google Scholar] [CrossRef]
- Ucar, D.; Kim, J.S.; Bishop, R.J.; Nussenblatt, R.B.; Rao, V.K.; Sen, H.N. Ocular Inflammatory Disorders in Autoimmune Lymphoproliferative Syndrome (ALPS). Ocul. Immunol. Inflamm. 2017, 25, 708–714. [Google Scholar] [CrossRef]
- Touhami, S.; Audo, I.; Terrada, C.; Gaudric, A.; LeHoang, P.; Touitou, V.; Bodaghi, B. Neoplasia and intraocular inflammation: From masquerade syndromes to immunotherapy-induced uveitis. Prog. Retin. Eye Res. 2019, 72, 100761. [Google Scholar] [CrossRef] [PubMed]
- Cunningham, E.T., Jr.; Moorthy, R.S.; Fraunfelder, F.W.; Zierhut, M. Vaccine-Associated Uveitis. Ocul. Immunol. Inflamm. 2019, 27, 517–520. [Google Scholar] [CrossRef] [PubMed]
- Cotte, P.; Pradat, P.; Kodjikian, L.; Jamilloux, Y.; Sève, P. Diagnostic value of lymphopaenia and elevated serum ACE in patients with uveitis. Br. J. Ophthalmol. 2020. [Google Scholar] [CrossRef] [PubMed]
- Niederer, R.L.; Al-Janabi, A.; Lightman, S.L.; Tomkins, O. Serum Angiotensin-Converting Enzyme Has a High Negative Predictive Value in the Investigation for Systemic Sarcoidosis. Am. J. Ophthalmol. 2018, 194, 82–87. [Google Scholar] [CrossRef] [PubMed]
- Gundlach, E.; Hoffmann, M.M.; Prasse, A.; Heinzelmann, S.; Neß, T. Interleukin-2 Receptor and Angiotensin-Converting Enzyme as Markers for Ocular Sarcoidosis. PLoS ONE 2016, 11, e0147258. [Google Scholar] [CrossRef] [PubMed]
- Sève, P.; Cacoub, P.; Bodaghi, B.; Trad, S.; Sellam, J.; Bellocq, D.; Bielefeld, P.; Sène, D.; Kaplanski, G.; Monnet, D.; et al. Uveitis: Diagnostic work-up. A literature review and recommendations from an expert committee. Autoimmun. Rev. 2017, 16, 1254–1264. [Google Scholar] [CrossRef]
- Sahin, O.; Ziaei, A.; Karaismailoglu, E.; Taheri, N. The serum angiotensin converting enzyme and lysozyme levels in patients with ocular involvement of autoimmune and infectious diseases. BMC Ophthalmol. 2016, 16, 1–9. [Google Scholar] [CrossRef]
- Bennett, D.; Cameli, P.; Lanzarone, N.; Carobene, L.; Bianchi, N.; Fui, A.; Rizzi, L.; Bergantini, L.; Cillis, G.; D’Alessandro, M.; et al. Chitotriosidase: A biomarker of activity and severity in patients with sarcoidosis. Respir. Res. 2020, 21, 1–12. [Google Scholar] [CrossRef]
- Dougados, M.; Baeten, D. Spondyloarthritis. Lancet 2011, 377, 2127–2137. [Google Scholar] [CrossRef]
- Stolwijk, C.; Van Tubergen, A.; Castillo-Ortiz, J.D.; Boonen, A. Prevalence of extra-articular manifestations in patients with ankylosing spondylitis: A systematic review and meta-analysis. Ann. Rheum. Dis. 2013, 74, 65–73. [Google Scholar] [CrossRef]
- Varkas, G.; Vastesaeger, N.; Cypers, H.; Colman, R.; Renson, T.; Van Praet, L.; Carron, P.; Raeman, F.; Devinck, M.; Gyselbrecht, L.; et al. Association of Inflammatory Bowel Disease and Acute Anterior Uveitis, but Not Psoriasis, With Disease Duration in Patients With Axial Spondyloarthritis. Arthritis Rheumatol. 2018, 70, 1588–1596. [Google Scholar] [CrossRef] [PubMed]
- De Winter, J.J.; Van Mens, L.J.; Van Der Heijde, D.; Landewé, R.; Baeten, D.L. Prevalence of peripheral and extra-articular disease in ankylosing spondylitis versus non-radiographic axial spondyloarthritis: A meta-analysis. Arthritis Res. 2016, 18, 1–11. [Google Scholar] [CrossRef]
- Arepalli, S.; Rosenbaum, J.T. The use of biologics for uveitis associated with spondyloarthritis. Curr. Opin. Rheumatol. 2019, 31, 349–354. [Google Scholar] [CrossRef]
- Biedermann, L.; Renz, L.; Fournier, N.; Rossel, J.-B.; Butter, M.; Bluemel, S.; Vavricka, S.R.; Rogler, G.; Scharl, M.; Anderegg, C.; et al. Uveitis manifestations in patients of the Swiss Inflammatory Bowel Disease Cohort Study. Ther. Adv. Gastroenterol. 2019, 12, 175628481986514. [Google Scholar] [CrossRef] [PubMed]
- Sharma, S.M.; Jackson, D. Uveitis in the Spondyloarthopathies. Best Pract. Res. Clin. Rheumatol. 2017, 31, 846–862. [Google Scholar] [CrossRef]
- Bengtsson, K.; Forsblad-D’Elia, H.; Deminger, A.; Klingberg, E.; Dehlin, M.; Exarchou, S.; Lindström, U.; Askling, J.; Jacobsson, L.T.H. Incidence of extra-articular manifestations in ankylosing spondylitis, psoriatic arthritis and undifferentiated spondyloarthritis: Results from a national register-based cohort study. Rheumatology 2020, keaa692. [Google Scholar] [CrossRef]
- Bacchiega, A.B.S.; Balbi, G.G.M.; Ochtrop, M.L.G.; De Andrade, F.A.; Levy, R.A.; Baraliakos, X. Ocular involvement in patients with spondyloarthritis. Rheumatology 2017, 56, 2060–2067. [Google Scholar] [CrossRef]
- Rosenbaum, J.T.; Dick, A.D. The Eyes Have it. Arthritis Rheumatol. 2018, 70, 1533–1543. [Google Scholar] [CrossRef]
- International Team for the Revision of the International Criteria for Behçet’s Disease (ITR-ICBD); Davatchi, F.; Assaadkhalil, S.H.; Calamia, K.T.; E Crook, J.; Sadeghiabdollahi, B.; Schirmer, M.; Tzellos, T.; Zouboulis, C.C.; Akhlagi, M.; et al. The International Criteria for Behçet’s Disease (ICBD): A collaborative study of 27 countries on the sensitivity and specificity of the new criteria. J. Eur. Acad. Dermatol. Venereol. 2013, 28, 338–347. [Google Scholar] [CrossRef]
- Yurdakul, S.; Günaydin, I.; Tüzün, Y.; Tankurt, N.; Pazarli, H.; Ozyazgan, Y.; Yazici, H. The prevalence of Behçet’s syndrome in a rural area in northern Turkey. J. Rheumatol. 1988, 15, 820–822. [Google Scholar]
- A Chamberlain, M. Behcet’s syndrome in 32 patients in Yorkshire. Ann. Rheum. Dis. 1977, 36, 491–499. [Google Scholar] [CrossRef] [PubMed]
- Davatchi, F. Behcet’s disease. Int. J. Rheum. Dis. 2014, 17, 355–357. [Google Scholar] [CrossRef] [PubMed]
- Internationalstudygroupforbehc Criteria for diagnosis of Behcet’s disease. Lancet 1990, 335. [CrossRef]
- Khairallah, M.; Accorinti, M.; Muccioli, C.; Kahloun, R.; Kempen, J.H. Epidemiology of Behçet Disease. Ocul. Immunol. Inflamm. 2012, 20, 324–335. [Google Scholar] [CrossRef]
- Ozyazgan, Y.; Ucar, D.; Hatemi, G.; Yazici, Y. Ocular Involvement of Behçet’s Syndrome: A Comprehensive Review. Clin. Rev. Allergy Immunol. 2014, 49, 298–306. [Google Scholar] [CrossRef]
- Davatchi, F.; Chams-Davatchi, C.; Shams, H.; Shahram, F.; Nadji, A.; Akhlaghi, M.; Faezi, T.; Ghodsi, Z.; Abdollahi, B.S.; Ashofteh, F.; et al. Behcet’s disease: Epidemiology, clinical manifestations, and diagnosis. Expert Rev. Clin. Immunol. 2016, 13, 57–65. [Google Scholar] [CrossRef]
- Sakthivel, P.; Bruder, D. Mechanism of granuloma formation in sarcoidosis. Curr. Opin. Hematol. 2017, 24, 59–65. [Google Scholar] [CrossRef]
- Costabel, U.; Hunninghake, G.W. on behalf of the Sarcoidosis Statement Committee ATS/ERS/WASOG statement on sarcoidosis. Eur. Respir. J. 1999, 14, 735–737. [Google Scholar] [CrossRef]
- Arkema, E.V.; Cozier, Y.C. Epidemiology of sarcoidosis: Current findings and future directions. Ther. Adv. Chronic Dis. 2018, 9, 227–240. [Google Scholar] [CrossRef]
- Pereira, C.A.; Dornfeld, M.C.; Baughman, R.; Judson, M.A. Clinical phenotypes in sarcoidosis. Curr. Opin. Pulm. Med. 2014, 20, 496–502. [Google Scholar] [CrossRef]
- Sève, P.; Jamilloux, Y.; Tilikete, C.; Gerfaud-Valentin, M.; Kodjikian, L.; El Jammal, T. Ocular Sarcoidosis. Semin. Respir. Crit. Care Med. 2020, 41, 673–688. [Google Scholar] [CrossRef] [PubMed]
- Jamilloux, Y.; Kodjikian, L.; Broussolle, C.; Sève, P. Sarcoidosis and uveitis. Autoimmun. Rev. 2014, 13, 840–849. [Google Scholar] [CrossRef] [PubMed]
- Dammacco, R.; Biswas, J.; Kivelä, T.T.; Zito, F.A.; Leone, P.; Mavilio, A.; Sisto, D.; Alessio, G.; Dammacco, F. Ocular sarcoidosis: Clinical experience and recent pathogenetic and therapeutic advancements. Int. Ophthalmol. 2020, 40, 3453–3467. [Google Scholar] [CrossRef] [PubMed]
- Brewerton, D.; Nicholls, A.; Caffrey, M.; Walters, D.; James, D. Acute Anterior Uveitis and HLA-B27. Lancet 1973, 302, 994–996. [Google Scholar] [CrossRef]
- Chang, J.H.; McCluskey, P.J.; Wakefield, D. Acute Anterior Uveitis and HLA-B27. Surv. Ophthalmol. 2005, 50, 364–388. [Google Scholar] [CrossRef] [PubMed]
- Kopplin, L.J.; Mount, G.; Suhler, E.B. Review for Disease of the Year: Epidemiology of HLA-B27 Associated Ocular Disorders. Ocul. Immunol. Inflamm. 2016, 24, 470–475. [Google Scholar] [CrossRef]
- Zeboulon, N.; Dougados, M.; Gossec, L. Prevalence and characteristics of uveitis in the spondyloarthropathies: A systematic literature review. Ann. Rheum. Dis. 2008, 67, 955–959. [Google Scholar] [CrossRef]
- Kim, M.; Sim, Y.S.; Choi, S.Y.; Park, Y.-H. Potential predictors for frequent relapse in human leukocyte antigen-B27-associated uveitis. Graefes Arch. Clin. Exp. Ophthalmol. 2018, 256, 1543–1549. [Google Scholar] [CrossRef]
- Suhler, E.B.; Martin, T.M.; Rosenbaum, J.T. HLA-B27 Associated uveitis: Overview and current perspectives. Curr. Opin. Ophthalmol. 2003, 14, 378–383. [Google Scholar] [CrossRef]
- Monnet, D. Ophthalmic findings and frequency of extraocular manifestations in patients with HLA-B27 uveitis*1A study of 175 cases. Ophthalmology 2004, 111, 802–809. [Google Scholar] [CrossRef]
- Pathanapitoon, K.; Dodds, E.M.; Cunningham, E.T.; Rothova, A. Clinical Spectrum of HLA-B27-Associated Ocular Inflammation. Ocul. Immunol. Inflamm. 2017, 25, 569–576. [Google Scholar] [CrossRef] [PubMed]
- Chung, Y.; Liao, H.; Lin, K.; Lin, Y.; Chou, C.; Chen, C.; Tsai, C. Prevalence of spondyloarthritis in 504 Chinese patients with HLA-B27-Associated acute anterior uveitis. Scand. J. Rheumatol. 2009, 38, 84–90. [Google Scholar] [CrossRef] [PubMed]
- Loh, A.R.; Acharya, N.R. Incidence Rates and Risk Factors for Ocular Complications and Vision Loss in HLA-B27-Associated Uveitis. Am. J. Ophthalmol. 2010, 150, 534–542. [Google Scholar] [CrossRef]
- Huhtinen, M. HLA-B27 typing in the categorisation of uveitis in a HLA-B27 rich population. Br. J. Ophthalmol. 2000, 84, 413–416. [Google Scholar] [CrossRef] [PubMed]
- El-Shabrawi, Y.; Wegscheider, B.J.; Weger, M.; Renner, W.; Posch, U.; Ulrich, S.; Ardjomand, N.; Hermann, J. Polymorphisms within the Tumor Necrosis Factor–α Promoter Region in Patients with HLA-B27–Associated Uveitis. Ophthalmology 2006, 113, 695–700. [Google Scholar] [CrossRef]
- Lindner, E.; Steinwender, G.; Plainer, S.; Poeschl, E.M.; Weger, M.; Ardjomand, N.; Renner, W.; El-Shabrawi, Y. Role of IL-10 gene polymorphisms in intermediate and HLA-B27-associated uveitis. Acta Ophthalmol. 2013, 91, e415–e417. [Google Scholar] [CrossRef]
- Steinwender, G.; Lindner, E.; Weger, M.; Plainer, S.; Renner, W.; Ardjomand, N.; El-Shabrawi, Y. Association between Polymorphism of the Vitamin D Metabolism Gene CYP27B1 and HLA-B27-Associated Uveitis. Is a State of Relative Immunodeficiency Pathogenic in HLA-B27-Positive Uveitis? PLoS ONE 2013, 8, e62244. [Google Scholar] [CrossRef]
- Huang, X.-F.; Li, Z.; De Guzman, E.; Robinson, P.; Gensler, L.; Ward, M.M.; Rahbar, M.H.; Lee, M.; Weisman, M.H.; Macfarlane, G.J.; et al. Genomewide Association Study of Acute Anterior Uveitis Identifies New Susceptibility Loci. Investig. Opthalmol. Vis. Sci. 2020, 61, 3. [Google Scholar] [CrossRef]
- Lu, M.-C.; Hsu, B.-B.; Koo, M.; Lai, N.-S. Higher risk of incident ankylosing spondylitis in patients with uveitis: A secondary cohort analysis of a nationwide, population-based health claims database. Scand. J. Rheumatol. 2017, 46, 468–473. [Google Scholar] [CrossRef]
- Wach, J.; Maucort-Boulch, D.; Kodjikian, L.; Iwaz, J.; Broussolle, C.; Sève, P. Acute anterior uveitis and undiagnosed spondyloarthritis: Usefulness of Berlin criteria. Graefes Arch. Clin. Exp. Ophthalmol. 2015, 253, 115–120. [Google Scholar] [CrossRef]
- Haroon, M.; O’Rourke, M.; Ramasamy, P.; Murphy, C.C.; Fitzgerald, O. A novel evidence-based detection of undiagnosed spondyloarthritis in patients presenting with acute anterior uveitis: The DUET (Dublin Uveitis Evaluation Tool). Ann. Rheum. Dis. 2015, 74, 1990–1995. [Google Scholar] [CrossRef] [PubMed]
- Oliveira, T.L.; Maksymowych, W.P.; Lambert, R.G.; Muccioli, C.; Fernandes, A.R.; Pinheiro, M.M. Sacroiliac Joint Magnetic Resonance Imaging in Asymptomatic Patients with Recurrent Acute Anterior Uveitis: A Proof-of-concept Study. J. Rheumatol. 2017, 44, 1833–1840. [Google Scholar] [CrossRef] [PubMed]
- Muñoz-Fernández, S.; Hidalgo, V.; Fernández-Melón, J.; Schlincker, A.; Bonilla, G.; Ruiz-Sancho, D.; Fonseca, A.; Gijón-Baños, J.; Martín-Mola, E. Sulfasalazine reduces the number of flares of acute anterior uveitis over a one-year period. J. Rheumatol. 2003, 30, 1277–1279. [Google Scholar] [PubMed]
- Benitez-Del-Castillo, J.M.; Garcia-Sanchez, J.; Iradier, T.; Bañares, A. Sulfasalazine in the prevention of anterior uveitis associated with ankylosing spondylitis. Eye 2000, 14, 340–343. [Google Scholar] [CrossRef] [PubMed]
- Muñoz-Fernández, S.; García-Aparicio, A.M.; Hidalgo, M.V.; Platero, M.; Schlincker, A.; Bascones, M.L.; Pombo, M.; Morente, P.; Sanpedro, J.; Martín-Mola, E. Methotrexate: An option for preventing the recurrence of acute anterior uveitis. Eye 2008, 23, 1130–1133. [Google Scholar] [CrossRef]
- Zu Hoerste, M.M.; Walscheid, K.; Tappeiner, C.; Zurek-Imhoff, B.; Heinz, C.; Heiligenhaus, A. The effect of methotrexate and sulfasalazine on the course of HLA-B27-positive anterior uveitis: Results from a retrospective cohort study. Graefes Arch. Clin. Exp. Ophthalmol. 2018, 256, 1985–1992. [Google Scholar] [CrossRef] [PubMed]
- Saadoun, D.; Bodaghi, B.; Bienvenu, B.; Wechsler, B.; Sene, D.; Trad, S.; Abad, S.; Cacoub, P.; Kodjikian, L.; Sève, P. Biotherapies in inflammatory ocular disorders: Interferons, immunoglobulins, monoclonal antibodies. Autoimmun. Rev. 2013, 12, 774–783. [Google Scholar] [CrossRef]
- Braun, J.; Baraliakos, X.; Listing, J.; Sieper, J. Decreased incidence of anterior uveitis in patients with ankylosing spondylitis treated with the anti-tumor necrosis factor agents infliximab and etanercept. Arthritis Rheum. 2005, 52, 2447–2451. [Google Scholar] [CrossRef]
- Rudwaleit, M.; Rødevand, E.; Holck, P.; Vanhoof, J.; Kron, M.; Kary, S.; Kupper, H. Adalimumab effectively reduces the rate of anterior uveitis flares in patients with active ankylosing spondylitis: Results of a prospective open-label study. Ann. Rheum. Dis. 2008, 68, 696–701. [Google Scholar] [CrossRef]
- Lie, E.; Lindström, U.; Zverkova-Sandström, T.; Olsen, I.C.; Forsblad-D’Elia, H.; Askling, J.; Kapetanovic, M.C.; Kristensen, L.E.; Jacobsson, L.T.H. Tumour necrosis factor inhibitor treatment and occurrence of anterior uveitis in ankylosing spondylitis: Results from the Swedish biologics register. Ann. Rheum. Dis. 2017, 76, 1515–1521. [Google Scholar] [CrossRef]
- Van Bentum, R.E.; Heslinga, S.C.; Nurmohamed, M.T.; Gerards, A.H.; Griep, E.N.; Koehorst, C.B.; Kok, M.R.; Schilder, A.M.; Verhoef, M.; E Van Der Horst-Bruinsma, I. Reduced Occurrence Rate of Acute Anterior Uveitis in Ankylosing Spondylitis Treated with Golimumab—The GO-EASY Study. J. Rheumatol. 2018, 46, 153–159. [Google Scholar] [CrossRef] [PubMed]
- Wendling, D.; Paccou, J.; Berthelot, J.-M.; Flipo, R.-M.; Guillaume-Czitrom, S.; Prati, C.; Dernis, E.; Direz, G.; Ferrazzi, V.; Ristori, J.-M. New Onset of Uveitis During Anti-Tumor Necrosis Factor Treatment for Rheumatic Diseases. Semin. Arthritis Rheum. 2011, 41, 503–510. [Google Scholar] [CrossRef] [PubMed]
- Gaujoux-Viala, C.; Giampietro, C.; Gaujoux, T.; Ea, H.-K.; Prati, C.; Orcel, P.; Wendling, D.; Lioté, F. Scleritis: A Paradoxical Effect of Etanercept? Etanercept-associated Inflammatory Eye Disease. J. Rheumatol. 2011, 39, 233–239. [Google Scholar] [CrossRef] [PubMed]
- Lim, L.L.; Fraunfelder, F.W.; Rosenbaum, J.T. Do tumor necrosis factor inhibitors cause uveitis? A registry-based study. Arthritis Rheum. 2007, 56, 3248–3252. [Google Scholar] [CrossRef] [PubMed]
- Lindström, U. Comparison of Anterior Uveitis Occurrence During Treatment with Secukinumab, Adalimumab, Infliximab and Etanercept in Spondyloarthritis. Ann. Rheum. Dis. 2020, 79. [Google Scholar] [CrossRef]
- Van Der Heijde, D.; Ramiro, S.; Landewé, R.; Baraliakos, X.; Bosch, F.V.D.; Sepriano, A.; Regel, A.; Ciurea, A.; Dagfinrud, H.; Dougados, M.; et al. 2016 update of the ASAS-EULAR management recommendations for axial spondyloarthritis. Ann. Rheum. Dis. 2017, 76, 978–991. [Google Scholar] [CrossRef]
- Sève, P.; Varron, L.; Broussolle, C.; Denis, P.; Kodjikian, L. Sarcoid-related Uveitis Occurring During Adalimumab Therapy. Ocul. Immunol. Inflamm. 2011, 20, 59–60. [Google Scholar] [CrossRef][Green Version]
- Dubinsky, M.C.; Cross, R.K.; Sandborn, W.J.; Long, M.; Song, X.; Shi, N.; Ding, Y.; Eichner, S.; Pappalardo, B.; Ganguli, A.; et al. Extraintestinal Manifestations in Vedolizumab and Anti-TNF-Treated Patients With Inflammatory Bowel Disease. Inflamm. Bowel Dis. 2018, 24, 1876–1882. [Google Scholar] [CrossRef]
- Bouzid, N.; Jamilloux, Y.; Chapurlat, R.; Pradat, P.; De Parisot, A.; Kodjikian, L.; Sève, P. Impact of systemic treatments on the course of HLA-B27-associated uveitis: A retrospective study of 101 patients. PLoS ONE 2020, 15, e0230560. [Google Scholar] [CrossRef]
- Zhong, Z.; Su, G.; Kijlstra, A.; Yang, P. Activation of the interleukin-23/interleukin-17 signalling pathway in autoinflammatory and autoimmune uveitis. Prog. Retin. Eye Res. 2020, 100866, 100866. [Google Scholar] [CrossRef]
- Deodhar, A.; Miceli-Richard, C.; Baraliakos, X.; Marzo-Ortega, H.; Gladman, D.D.; Blanco, R.; Das Gupta, A.; Martin, R.; Safi, J.; Porter, B.; et al. Incidence of Uveitis in Secukinumab-treated Patients With Ankylosing Spondylitis: Pooled Data Analysis From Three Phase 3 Studies. ACR Open Rheumatol. 2020, 2, 294–299. [Google Scholar] [CrossRef] [PubMed]
- Van Der Heijde, D.; Gladman, D.D.; Kishimoto, M.; Okada, M.; Rathmann, S.S.; Moriarty, S.R.; Shuler, C.L.; Carlier, H.; Benichou, O.; Yi, E. Efficacy and Safety of Ixekizumab in Patients with Active Psoriatic Arthritis: 52-week Results from a Phase III Study (SPIRIT-P1). J. Rheumatol. 2017, 45, 367–377. [Google Scholar] [CrossRef] [PubMed]
- Saadoun, D.; Weschler, B. Behçet’s Disease. Orphanet. J. Rare Dis. 2012, 7. [Google Scholar] [CrossRef]
- Tugal-Tutkun, I.; Onal, S.; Altan-Yaycioglu, R.; Altunbas, H.H.; Urgancioglu, M. Uveitis in Behçet disease: An analysis of 880 patients. Am. J. Ophthalmol. 2004, 138, 373–380. [Google Scholar] [CrossRef] [PubMed]
- Taylor, S.R.; Singh, J.; Menezo, V.; Wakefield, D.; McCluskey, P.; Lightman, S. Behçet Disease: Visual Prognosis and Factors Influencing the Development of Visual Loss. Am. J. Ophthalmol. 2011, 152, 1059–1066. [Google Scholar] [CrossRef]
- Takeuchi, M.; Hokama, H.; Tsukahara, R.; Kezuka, T.; Goto, H.; Sakai, J.-I.; Usui, M. Risk and prognostic factors of poor visual outcome in Behcet’s disease with ocular involvement. Graefes Arch. Clin. Exp. Ophthalmol. 2005, 243, 1147–1152. [Google Scholar] [CrossRef]
- Accorinti, M.; Pesci, F.R.; Pirraglia, M.P.; Abicca, I.; Pivetti-Pezzi, P. Ocular Behçet’s Disease: Changing Patterns Over Time, Complications and Long-Term Visual Prognosis. Ocul. Immunol. Inflamm. 2016, 25, 29–36. [Google Scholar] [CrossRef]
- El Latif, E.A.; Galal, M.A.K.F.; A Tawfik, M.; Elmoddather, M.; Nooreldin, A.; Yousef, H.S. Pattern of Uveitis Associated with Behçet’s Disease in an Egyptian Cohort. Clin. Ophthalmol. 2020, 14, 4005–4014. [Google Scholar] [CrossRef]
- Davatchi, F.; Abdollahi, B.S.; Chams-Davatchi, C.; Shahram, F.; Nadji, A.; Shams, H.; Faezi, T.; Akhlaghi, M.; Ashofteh, F.; Mataji, M.; et al. Validation of the revised International Criteria for Behcet’s Disease (ICBD) in Iran. Clin. Rheumatol. 2013, 34, 315–320. [Google Scholar] [CrossRef]
- Tugal-Tutkun, I.; Onal, S.; Stanford, M.; Akman, M.; Twisk, J.W.; Boers, M.; Oray, M.; Özdal, P.Ç.; Kadayifcilar, S.; Amer, R.; et al. An Algorithm for the Diagnosis of Behçet Disease Uveitis in Adults. Ocul. Immunol. Inflamm. 2020, 1–10. [Google Scholar] [CrossRef]
- Hatemi, G.; Christensen, R.; Bang, D.; Bodaghi, B.; Celik, A.F.; Fortune, F.; Gaudric, J.; Gül, A.; Kötter, I.; Leccese, P.; et al. 2018 update of the EULAR recommendations for the management of Behçet’s syndrome. Ann. Rheum. Dis. 2018, 77, 808–818. [Google Scholar] [CrossRef] [PubMed]
- Karadağ, Ö.; Bolek, E.C. Management of Behcet’s syndrome. Rheumatology 2020, 59, iii108–iii117. [Google Scholar] [CrossRef] [PubMed]
- Akman-Demir, G.; Ayranci, O.; Kurtuncu, M.; Vanli, E.N.; Mutlu, M.; Tugal-Tutkun, I. Cyclosporine for Behçet’s uveitis: Is it associated with an increased risk of neurological involvement? Clin. Exp. Rheumatol. 2008, 26, 7. [Google Scholar]
- Saadoun, D.; Wechsler, B.; Terrada, C.; Hajage, D.; Huong, D.L.T.; Resche-Rigon, M.; Cassoux, N.; Le Hoang, P.; Amoura, Z.; Bodaghi, B.; et al. Azathioprine in severe uveitis of Behçet’s disease. Arthritis Rheum. 2010, 62, 1733–1738. [Google Scholar] [CrossRef]
- Ohno, S.; Umebayashi, I.; Matsukawa, M.; Goto, T.; Yano, T. Safety and efficacy of infliximab in the treatment of refractory uveoretinitis in Behçet’s disease: A large-scale, long-term postmarketing surveillance in Japan. Arthritis Res. 2019, 21, 2. [Google Scholar] [CrossRef]
- Tugal-Tutkun, I.; Özdal, P. Çakar Behçet’s disease uveitis: Is there a need for new emerging drugs? Expert Opin. Emerg. Drugs 2020, 25, 531–547. [Google Scholar] [CrossRef]
- Atienza-Mateo, B.; Martín-Varillas, J.L.; Calvo-Río, V.; Demetrio-Pablo, R.; Beltrán, E.; Sánchez-Bursón, J.; Mesquida, M.; Adan, A.; Hernández, M.V.; Hernández-Garfella, M.; et al. Comparative Study of Infliximab Versus Adalimumab in Refractory Uveitis due to Behçet’s Disease: National Multicenter Study of 177 Cases. Arthritis Rheumatol. 2019, 71, 2081–2089. [Google Scholar] [CrossRef]
- Ozguler, Y.; Leccese, P.; Christensen, R.; Esatoglu, S.N.; Bang, D.; Bodaghi, B.; Çelik, A.F.; Fortune, F.; Gaudric, J.; Gül, A.; et al. Management of major organ involvement of Behçet’s syndrome: A systematic review for update of the EULAR recommendations. Rheumatology 2018, 57, 2200–2212. [Google Scholar] [CrossRef]
- Diwo, E.; Gueudry, J.; Saadoun, D.; Weschler, B.; LeHoang, P.; Bodaghi, B. Long-term Efficacy of Interferon in Severe Uveitis Associated with Behçet Disease. Ocul. Immunol. Inflamm. 2017, 25, 76–84. [Google Scholar] [CrossRef]
- Celiker, H.; Kazokoglu, H.; Direskeneli, H. Factors Affecting Relapse and Remission in Behçet’s Uveitis Treated with Interferon Alpha2a. J. Ocul. Pharmacol. Ther. 2019, 35, 58–65. [Google Scholar] [CrossRef]
- Yalçindag, N.; Köse, H.C. Comparison of the Treatment Results for Behçet Uveitis in Patients Treated with Infliximab and Interferon. Ocul. Immunol. Inflamm. 2020, 28, 305–314. [Google Scholar] [CrossRef] [PubMed]
- Bettiol, A.; Silvestri, E.; Di Scala, G.; Amedei, A.; Becatti, M.; Fiorillo, C.; Lopalco, G.; Salvarani, C.; Cantarini, L.; Soriano, A.; et al. The right place of interleukin-1 inhibitors in the treatment of Behçet’s syndrome: A systematic review. Rheumatol. Int. 2019, 39, 971–990. [Google Scholar] [CrossRef] [PubMed]
- Tugal-Tutkun, I.; Pavesio, C.; De Cordoue, A.; Bernard-Poenaru, O.; Gül, A. Use of Gevokizumab in Patients with Behçet’s Disease Uveitis: An International, Randomized, Double-Masked, Placebo-Controlled Study and Open-Label Extension Study. Ocul. Immunol. Inflamm. 2018, 26, 1023–1033. [Google Scholar] [CrossRef] [PubMed]
- Fabiani, C.; Vitale, A.; Emmi, G.; Lopalco, G.; Vannozzi, L.; Guerriero, S.; Gentileschi, S.; Bacherini, D.; Franceschini, R.; Frediani, B.; et al. Interleukin (IL)-1 inhibition with anakinra and canakinumab in Behçet’s disease-related uveitis: A multicenter retrospective observational study. Clin. Rheumatol. 2017, 36, 191–197. [Google Scholar] [CrossRef] [PubMed]
- Lightman, S.; Taylor, S.R.J.; Bunce, C.; Longhurst, H.; Lynn, W.; Moots, R.; Stanford, M.; Tomkins-Netzer, O.; Yang, D.; Calder, V.L.; et al. Pegylated interferon-α-2b reduces corticosteroid requirement in patients with Behçet’s disease with upregulation of circulating regulatory T cells and reduction of Th17. Ann. Rheum. Dis. 2014, 74, 1138–1144. [Google Scholar] [CrossRef] [PubMed]
- Buggage, R.R.; Levy-Clarke, G.; Sen, H.N.; Ursea, R.; Srivastava, S.K.; Suhler, E.B.; Altemare, C.; Velez, G.; Ragheb, J.; Chan, C.-C.; et al. A Double-masked, Randomized Study to Investigate the Safety and Efficacy of Daclizumab to Treat the Ocular Complications Related to Behçet’s Disease. Ocul. Immunol. Inflamm. 2007, 15, 63–70. [Google Scholar] [CrossRef] [PubMed]
- Dick, A.D.; Tugal-Tutkun, I.; Foster, S.; Zierhut, M.; Liew, S.M.; Bezlyak, V.; Androudi, S. Secukinumab in the Treatment of Noninfectious Uveitis: Results of Three Randomized, Controlled Clinical Trials. Ophthalmology 2013, 120, 777–787. [Google Scholar] [CrossRef] [PubMed]
- Davatchi, F.; Shams, H.; Rezaipoor, M.; Abdollahi, B.S.; Shahram, F.; Nadji, A.; Chams-Davatchi, C.; Akhlaghi, M.; Faezi, T.; Naderi, N. Rituximab in intractable ocular lesions of Behcet’s disease; randomized single-blind control study (pilot study). Int. J. Rheum. Dis. 2010, 13, 246–252. [Google Scholar] [CrossRef]
- Martín-Varillas, J.L.; Calvo-Río, V.; Beltrán, E.; Sánchez-Bursón, J.; Mesquida, M.; Adán, A.; Hernandez, V.; Garfella, M.H.; Pascual, E.V.; Martínez-Costa, L.; et al. Successful Optimization of Adalimumab Therapy in Refractory Uveitis Due to Behçet’s Disease. Ophthalmology 2018, 125, 1444–1451. [Google Scholar] [CrossRef]
- Pichi, F.; Smith, S.D.; Neri, P.; Woodstock, E.; Hay, S.; Parrulli, S.; Corvi, F.; Mapelli, C.; Invernizzi, A. Choroidal Granulomas Visualized by Swept-Source Optical Coherence Tomography Angiography. Retina 2020. [Google Scholar] [CrossRef]
- Coulon, C.; Kodjikian, L.; Rochepeau, C.; Perard, L.; Jardel, S.; Burillon, C.; Broussolle, C.; Jamilloux, Y.; Sève, P. Ethnicity and association with ocular, systemic manifestations and prognosis in 194 patients with sarcoid uveitis. Graefe’s Arch. Clin. Exp. Ophthalmol. 2019, 257, 2495–2503. [Google Scholar] [CrossRef] [PubMed]
- Birnbaum, A.D.; French, D.D.; Mirsaeidi, M.; Wehrli, S. Sarcoidosis in the National Veteran Population. Ophthalmology 2015, 122, 934–938. [Google Scholar] [CrossRef] [PubMed]
- Pasadhika, S.; Rosenbaum, J.T. Ocular Sarcoidosis. Clin. Chest Med. 2015, 36, 669–683. [Google Scholar] [CrossRef] [PubMed]
- Ma, S.P.; Rogers, S.L.; Hall, A.J.; Hodgson, L.; Brennan, J.; Stawell, R.J.; Lim, L.L. Sarcoidosis-related Uveitis: Clinical Presentation, Disease Course, and Rates of Systemic Disease Progression After Uveitis Diagnosis. Am. J. Ophthalmol. 2019, 198, 30–36. [Google Scholar] [CrossRef] [PubMed]
- Zaidi, A.A.; Ying, G.-S.; Daniel, E.; Gangaputra, S.; Rosenbaum, J.T.; Suhler, E.B.; Thorne, J.E.; Foster, C.S.; Jabs, D.A.; Levy-Clarke, G.A.; et al. Hypopyon in Patients with Uveitis. Ophthalmology 2010, 117, 366–372. [Google Scholar] [CrossRef]
- Evans, M.; Sharma, O.; LaBree, L.; Smith, R.E.; Rao, N.A. Differences in Clinical Findings between Caucasians and African Americans with Biopsy-Proven Sarcoidosis. Ophthalmology 2007, 114, 325–333. [Google Scholar] [CrossRef]
- Neß, T.; Böhringer, D.; Heinzelmann, S. Intermediate uveitis: Pattern of etiology, complications, treatment and outcome in a tertiary academic center. Orphanet J. Rare Dis. 2017, 12, 1–7. [Google Scholar] [CrossRef]
- Herbort, C.P.; A Rao, N.; Mochizuki, M.; The Members of The Scientific members of Scientific Committee of First International Workshop on Ocular Sarcoidosis. International Criteria for the Diagnosis of Ocular Sarcoidosis: Results of the First International Workshop on Ocular Sarcoidosis (IWOS). Ocul. Immunol. Inflamm. 2009, 17, 160–169. [Google Scholar] [CrossRef]
- Rothova, A. Ocular involvement in sarcoidosis. Br. J. Ophthalmol. 2000, 84, 110–116. [Google Scholar] [CrossRef]
- Kluger, N. Tattoo-associated uveitis with or without systemic sarcoidosis: A comparative review of the literature. J. Eur. Acad. Dermatol. Venereol. 2018, 32, 1852–1861. [Google Scholar] [CrossRef]
- Rochepeau, C.; Jamilloux, Y.; Kerever, S.; Febvay, C.; Perard, L.; Broussolle, C.; Burillon, C.; Kodjikian, L.; Seve, P. Long-term visual and systemic prognoses of 83 cases of biopsy-proven sarcoid uveitis. Br. J. Ophthalmol. 2016, 101, 856–861. [Google Scholar] [CrossRef] [PubMed]
- Edelsten, C.; Pearson, A.; Joynes, E.; Stanford, M.R.; Graham, E.M. The ocular and systemic prognosis of patients presenting with sarcoid uveitis. Eye 1999, 13, 748–753. [Google Scholar] [CrossRef] [PubMed]
- Han, Y.S.; Rivera-Grana, E.; Salek, S.; Rosenbaum, J.T. Distinguishing Uveitis Secondary to Sarcoidosis From Idiopathic Disease. JAMA Ophthalmol. 2018, 136, 109–115. [Google Scholar] [CrossRef] [PubMed]
- Dana, M.-R.; Merayo-Lloves, J.; Schaumberg, D.A.; Foster, C.S. Prognosticators for Visual Outcome in Sarcoid Uveitis. Ophthalmology 1996, 103, 1846–1853. [Google Scholar] [CrossRef]
- Shaw, J.A.; Smit, D.; Griffith-Richards, S.; Koegelenberg, C.F.N. Utility of routine chest radiography in ocular tuberculosis and sarcoidosis. Int. J. Tuberc. Lung Dis. 2018, 22, 1374–1377. [Google Scholar] [CrossRef]
- Rothova, A.; Groen, F. Ocular Involvement in Sarcoidosis. Semin. Respir. Crit. Care Med. 2017, 38, 514–522. [Google Scholar] [CrossRef]
- Birnbaum, A.D.; Oh, F.S.; Chakrabarti, A.; Tessler, H.H.; Goldstein, D.A. Clinical Features and Diagnostic Evaluation of Biopsy-Proven Ocular Sarcoidosis. Arch. Ophthalmol. 2011, 129, 409–413. [Google Scholar] [CrossRef]
- Takada, K.; Matsumoto, S.; Kojima, E.; Iwata, S.; Tanaka, K. Diagnostic management of patients with suspected ocular sarcoidosis. J. Thorac. Dis. 2013, 5, 135–140. [Google Scholar]
- Chung, Y.-M.; Lin, Y.-C.; Liu, Y.-T.; Chung, Y.-M.; Liu, H.-N.; Hsu, W.-H. Uveitis with Biopsy-proven Sarcoidosis in Chinese—A Study of 60 Patients in a Uveitis Clinic Over a Period of 20 Years. J. Chin. Med. Assoc. 2007, 70, 492–496. [Google Scholar] [CrossRef][Green Version]
- Kaiser, P.K.; Lowder, C.Y.; Sullivan, P.; Sanislo, S.R.; Kosmorsky, G.S.; A Meziane, M.; Rice, T.W.; Smith, S.D.; Meisler, D.M. Chest computerized tomography in the evaluation of uveitis in elderly women. Am. J. Ophthalmol. 2002, 133, 499–505. [Google Scholar] [CrossRef]
- Febvay, C.; Kodjikian, L.; Maucort-Boulch, D.; Perard, L.; Iwaz, J.; Jamilloux, Y.; Broussolle, C.; Burillon, C.; Seve, P. Clinical features and diagnostic evaluation of 83 biopsy-proven sarcoid uveitis cases. Br. J. Ophthalmol. 2015, 99, 1372–1376. [Google Scholar] [CrossRef] [PubMed]
- Clement, D.S.; Postma, G.; Rothova, A.; Grutters, J.C.; Prokop, M.; De Jong, P.A. Intraocular sarcoidosis: Association of clinical characteristics of uveitis with positive chest high-resolution computed tomography findings. Br. J. Ophthalmol. 2009, 94, 219–222. [Google Scholar] [CrossRef] [PubMed]
- Rahmi, A.; Deshayes, E.; Maucort-Boulch, D.; Varron, L.; Grange, J.D.; Kodjikian, L.; Seve, P. Intraocular sarcoidosis: Association of clinical characteristics of uveitis with findings from18F-labelled fluorodeoxyglucose positron emission tomography. Br. J. Ophthalmol. 2011, 96, 99–103. [Google Scholar] [CrossRef]
- Chauvelot, P.; Skanjeti, A.; Jamilloux, Y.; De Parisot, A.; Broussolle, C.; Denis, P.; Ramackers, J.M.; Giammarile, F.; Kodjikian, L.; Sève, P. 18F-fluorodeoxyglucose positron emission tomography is useful for the diagnosis of intraocular sarcoidosis in patients with a normal CT scan. Br. J. Ophthalmol. 2019, 103, 1650–1655. [Google Scholar] [CrossRef] [PubMed]
- Bernard, C.; Kodjikian, L.; Bancel, B.; Isaac, S.; Broussolle, C.; Sève, P. Ocular sarcoidosis: When should labial salivary gland biopsy be performed? Graefes Arch. Clin. Exp. Ophthalmol. 2012, 251, 855–860. [Google Scholar] [CrossRef]
- Hadjadj, J.; Dechartres, A.; Chapron, T.; Assala, M.; Salah, S.; Dunogué, B.; Musset, L.; Baudin, B.; Groh, M.; Blanche, P.; et al. Relevance of diagnostic investigations in patients with uveitis: Retrospective cohort study on 300 patients. Autoimmun. Rev. 2017, 16, 504–511. [Google Scholar] [CrossRef]
- Takahashi, T.; Azuma, A.; Abe, S.; Kawanami, O.; Ohara, K.; Kudoh, S. Significance of lymphocytosis in bronchoalveolar lavage in suspected ocular sarcoidosis. Eur. Respir. J. 2001, 18, 515–521. [Google Scholar] [CrossRef]
- Ohmichi, M. [Histologic diagnosis of sarcoidosis]. Nihon rinsho. Jpn. J. Clin. Med. 2002, 60, 1759–1765. [Google Scholar]
- Ohara, K.; Okubo, A.; Kamata, K.; Sasaki, H.; Kobayashi, J.; Kitamura, S. Transbronchial Lung Biopsy in the Diagnosis of Suspected Ocular Sarcoidosis. Arch. Ophthalmol. 1993, 111, 642–644. [Google Scholar] [CrossRef]
- De Boer, S.; Milne, D.G.; Zeng, I.; Wilsher, M.L. Does CT scanning predict the likelihood of a positive transbronchial biopsy in sarcoidosis? Thorax 2009, 64, 436–439. [Google Scholar] [CrossRef]
- Mochizuki, M.; Smith, J.R.; Takase, H.; Kaburaki, T.; Acharya, N.R.; A Rao, N. Revised criteria of International Workshop on Ocular Sarcoidosis (IWOS) for the diagnosis of ocular sarcoidosis. Br. J. Ophthalmol. 2019, 103, 1418–1422. [Google Scholar] [CrossRef] [PubMed]
- Takase, H.; Shimizu, K.; Yamada, Y.; Hanada, A.; Takahashi, H.; Mochizuki, M. Validation of international criteria for the diagnosis of ocular sarcoidosis proposed by the first international workshop on ocular sarcoidosis. Jpn. J. Ophthalmol. 2010, 54, 529–536. [Google Scholar] [CrossRef] [PubMed]
- Acharya, N.R.; Browne, E.N.; Rao, N.; Mochizuki, M. Distinguishing Features of Ocular Sarcoidosis in an International Cohort of Uveitis Patients. Ophthalmology 2018, 125, 119–126. [Google Scholar] [CrossRef] [PubMed]
- Handa-Miyauchi, M.; Takase, H.; Tanaka, M.; Akiyama, M.; Ohno-Matsui, K.; Mochizuki, M. A Validation Study of the Revised Diagnostic Criteria from the International Workshop on Ocular Sarcoidosis at a Single Institute in Japan. Ocul. Immunol. Inflamm. 2020, 1–6. [Google Scholar] [CrossRef]
- Baughman, R.P.; E Lower, E.; Ingledue, R.; Kaufman, A.H. Management of ocular sarcoidosis. Sarcoidosis Vasc. Diffus. Lung Dis. Off. J. WASOG 2012, 29, 26–33. [Google Scholar]
- Baughman, R.P.; E Lower, E.; A Bradley, D.; A Raymond, L.; Kaufman, A. Etanercept for Refractory Ocular Sarcoidosis. Chest 2005, 128, 1062–1067. [Google Scholar] [CrossRef]
- Maneiro, J.R.; Salgado, E.; Gomez-Reino, J.J.; Carmona, L. Efficacy and Safety of TNF Antagonists in Sarcoidosis: Data from the Spanish Registry of Biologics BIOBADASER and a Systematic Review. Semin. Arthritis Rheum. 2012, 42, 89–103. [Google Scholar] [CrossRef]
- El Jammal, T.; Jamilloux, Y.; Gerfaud-Valentin, M.; Valeyre, D.; Sève, P. Refractory Sarcoidosis: A Review. Ther. Clin. Risk Manag. 2020, 16, 323–345. [Google Scholar] [CrossRef]
- Riancho-Zarrabeitia, L.; Calvo-Río, V.; Blanco, R.; Mesquida, M.; Adan, A.M.; Herreras, J.M.; Aparicio, Á.; Peiteado-Lopez, D.; Cordero-Coma, M.; Serrano, J.L.G.; et al. Anti-TNF-α therapy in refractory uveitis associated with sarcoidosis: Multicenter study of 17 patients. Semin. Arthritis Rheum. 2015, 45, 361–368. [Google Scholar] [CrossRef]
- Erckens, R.J.; Mostard, R.L.M.; Wijnen, P.A.H.M.; Schouten, J.S.A.G.; Drent, M. Adalimumab successful in sarcoidosis patients with refractory chronic non-infectious uveitis. Graefes Arch. Clin. Exp. Ophthalmol. 2011, 250, 713–720. [Google Scholar] [CrossRef]
- Marquet, A.; Chapelon-Abric, C.; Maucort-Boulch, D.; Cohen-Aubart, F.; Pérard, L.; Bouillet, L.; Abad, S.; Bielefeld, P.; Bouvry, D.; André, M.; et al. Efficacy and Safety of TNF Antagonists in Ocular Sarcoidosis: Data from the French Registry STAT. Sarcoidosis Vasc Diffus. Lung Dis. 2017, 34, 74. [Google Scholar]
- Sève, P.; Kodjikian, L.; Adélaïde, L.; Jamilloux, Y. Uveitis in adults: What do rheumatologists need to know? Jt. Bone Spine 2015, 82, 308–314. [Google Scholar] [CrossRef] [PubMed]
- Wartique, L.; Jamilloux, Y.; Bernecourt, A.D.P.D.; Kodjikian, L.; Ghesquieres, H.; Ide, C.; Sève, P. Development of Vitreoretinal Lymphoma in a Patient with Sarcoid Uveitis. Ocul. Immunol. Inflamm. 2019, 28, 647–650. [Google Scholar] [CrossRef] [PubMed]
- Beccastrini, E.; Vannozzi, L.; Bacherini, D.; Squatrito, D.; Emmi, L. Successful Treatment of Ocular Sarcoidosis with Rituximab. Ocul. Immunol. Inflamm. 2013, 21, 244–246. [Google Scholar] [CrossRef]
- Baughman, R.P.; Lower, E.E.; Kaufman, A.H. Rituximab for refractory granulomatous eye disease. Clin. Ophthalmol. 2012, 6, 1613. [Google Scholar] [CrossRef][Green Version]
- Silpa-Archa, S.; Oray, M.; Preble, J.M.; Foster, C.S. Outcome of tocilizumab treatment in refractory ocular inflammatory diseases. Acta Ophthalmol. 2016, 94, e400–e406. [Google Scholar] [CrossRef]
- Sejournet, L.; Kodjikian, L.; Grange, L.; Grumet, P.; Jamilloux, Y.; Sève, P. Resolution of ocular and mediastinal sarcoidosis after Janus kinase inhibitor therapy for concomitant rheumatoid arthritis. Clin. Exp. Rheumatol. 2020. online ahead of print. [Google Scholar]
- Dave, N.; Chevour, P.; Mahendradas, P.; Venkatesh, A.; Kawali, A.; Shetty, R.; Ghosh, A.; Sethu, S. Increased Aqueous Humor CD4+/CD8+ Lymphocyte Ratio in Sarcoid Uveitis. Ocul. Immunol. Inflamm. 2019, 27, 1033–1040. [Google Scholar] [CrossRef]
- Bonacini, M.; Soriano, A.; Cimino, L.; De Simone, L.; Bolletta, E.; Gozzi, F.; Muratore, F.; Nicastro, M.; Belloni, L.; Zerbini, A.; et al. Cytokine Profiling in Aqueous Humor Samples From Patients With Non-Infectious Uveitis Associated With Systemic Inflammatory Diseases. Front. Immunol. 2020, 11, 358. [Google Scholar] [CrossRef]
- Carreño, E.; Portero, A.; Herreras, J.M.; García-Vázquez, C.; Whitcup, S.M.; Stern, M.E.; Calonge, M.; Enríquez-De-Salamanca, A. Cytokine and chemokine tear levels in patients with uveitis. Acta Ophthalmol. 2017, 95, e405–e414. [Google Scholar] [CrossRef]
- Choi, R.Y.; Rivera-Grana, E.; Rosenbaum, J.T. Reclassifying Idiopathic Uveitis: Lessons From a Tertiary Uveitis Center. Am. J. Ophthalmol. 2019, 198, 193–199. [Google Scholar] [CrossRef] [PubMed]

|
|
| 1. Mutton-fat keratic precipitates(large or small) and/or iris nodules at pupillary margin (Koeppe) or in stroma (Busacca) |
| 2. Trabecular meshwork nodules and/or tent-shaped peripheral anterior synechia |
| 3. Snowballs/strings of pearls vitreous opacities |
| 4. Multiple chorioretinal peripheral lesions (active and/or atrophic) |
| 5. Nodular and/or segmental periphlebitis (±candle-wax drippings) and/or macroaneurysm in an inflamed eye |
| 6. Optic-disc nodule(s)/granuloma(s) and/or solitary choroidal nodule |
| 7. Bilaterality (assessed by ophthalmological examination including ocular imaging showing subclinical inflammation) |
|
| 1. Bilateral hilar lymphadenopathy on chest X-ray and/or chest computed CT scan |
| 2. Negative tuberculin test in a BCG-vaccinated patient or interferon-gamma releasing assays |
| 3. Elevated serum angiotensin converting-enzyme |
| 4. Elevated serum lysozyme |
| 5. Elevated CD4/CD8 ratio (>3.5) in bronchoalvelar lavage fluid |
| 6. Abnormal label uptake on 67-gallium scintigraphy or 18F-fluorodesoxyglucose positron emission tomography imaging |
| 7. Lymphopenia |
| 8. Parenchymal lung changes consistent with sarcoidosis, as determined by pneumologists or radiologists |
| Diagnostic criteria of ocular sarcoidosis |
| Diagnostic criteria of ocular sarcoidosis were established in 3 levels of certainty: |
|
|
|
Publisher’s Note: MDPI stays neutral with regard to jurisdictional claims in published maps and institutional affiliations. |
© 2021 by the authors. Licensee MDPI, Basel, Switzerland. This article is an open access article distributed under the terms and conditions of the Creative Commons Attribution (CC BY) license (http://creativecommons.org/licenses/by/4.0/).
Share and Cite
El Jammal, T.; Loria, O.; Jamilloux, Y.; Gerfaud-Valentin, M.; Kodjikian, L.; Sève, P. Uveitis as an Open Window to Systemic Inflammatory Diseases. J. Clin. Med. 2021, 10, 281. https://doi.org/10.3390/jcm10020281
El Jammal T, Loria O, Jamilloux Y, Gerfaud-Valentin M, Kodjikian L, Sève P. Uveitis as an Open Window to Systemic Inflammatory Diseases. Journal of Clinical Medicine. 2021; 10(2):281. https://doi.org/10.3390/jcm10020281
Chicago/Turabian StyleEl Jammal, Thomas, Olivier Loria, Yvan Jamilloux, Mathieu Gerfaud-Valentin, Laurent Kodjikian, and Pascal Sève. 2021. "Uveitis as an Open Window to Systemic Inflammatory Diseases" Journal of Clinical Medicine 10, no. 2: 281. https://doi.org/10.3390/jcm10020281
APA StyleEl Jammal, T., Loria, O., Jamilloux, Y., Gerfaud-Valentin, M., Kodjikian, L., & Sève, P. (2021). Uveitis as an Open Window to Systemic Inflammatory Diseases. Journal of Clinical Medicine, 10(2), 281. https://doi.org/10.3390/jcm10020281

